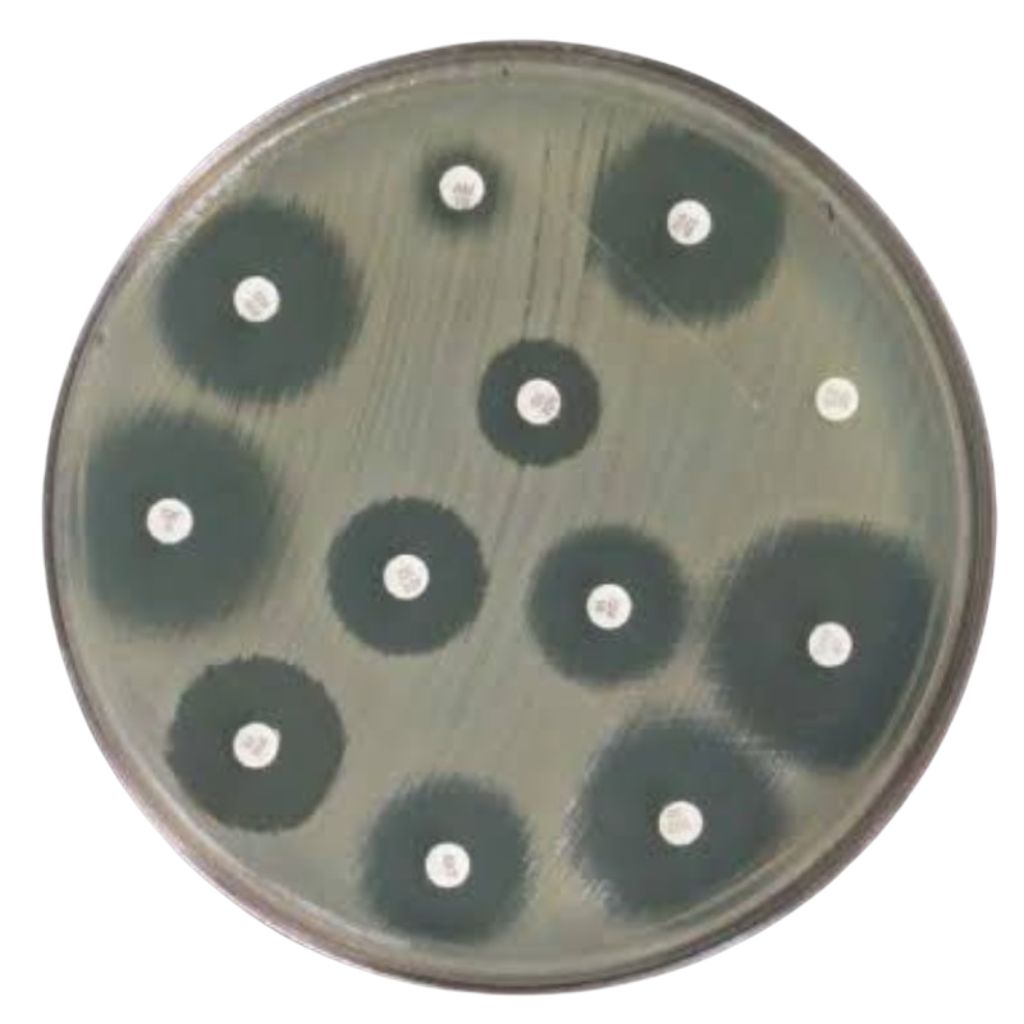
Medical team

About
The Kenya Association of Clinical Pathologists (KACP) was established by a dedicated group of professionals in clinical pathology to advance excellence in laboratory medicine and enhance patient care across Kenya and the East Africa region. Our members provide a forum for presenting, discussing, and critically evaluating scientific, technological, and methodological advances in pathology.
Our Mission and Vision
To be a leading professional association empowering clinical pathologists and laboratory medicine specialists to deliver high-quality diagnostic services that improve healthcare outcomes in Kenya and beyond.
To advance the study and practice of clinical pathology through education, scientific exchange, research, and advocacy, while promoting professional standards and ethical conduct.

Our Core Values
These principles guide everything we do in our commitment to exceptional Clinical Pathology
Education
Supporting continuous professional development and knowledge sharing.
Excellence
Upholding high technical and ethical standards in all activities.
Collaboration
Fostering partnerships among professionals and institutions.
Innovation
Encouraging scientific inquiry and adoption of best laboratory practices.
Collaborations & Partnerships
KACP works with local and international partners to advance excellence in pathology and laboratory medicine. These collaborations support training, research, innovation, and improved diagnostic services for better healthcare outcomes.





